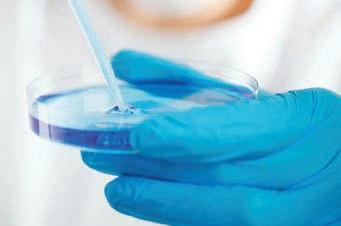

2 minute read
CARING FOR CANCER WITHOUT ANIMAL EXPERIMENTS IS THIS TRUST’S AIM
[ANIMAL-FREE CANCER RESEARCH

Advertisement
is the ethos of the Caring Cancer Trust (CCT), which funds groundbreaking, ethical, animal-free research into cancer, its non-invasive treatment, cure and prevention.

CCT has its own ‘Stopcancer’ laboratory research programme that does not use live animals or embryonic stem cells. Over the past 20 years CCT-funded oncology researchers have discovered potential new causes of children’s cancer, developed new treatments for earlystage cervical cancer and are now advancing knowledge for the prevention of cancer.
Cancer prevention
Humans are now living longer than ever before. Unfortunately, this increased life expectancy has been accompanied by an increase in many age-related disorders. Indeed, the COVID-19 pandemic has highlighted age-related increased susceptibility to viral infections, which occurs in older people.
Age-related damage to cells has by far the greatest influence on human health promoting the development of not only cancer, but cardiovascular, neurodegenerative and autoimmune diseases.
Current opinion is that novel treatments which inhibit cellular ageing have the potential to reduce the development of cancer and all these ailments simultaneously rather than having to treat each separately. Most notably, such treatments will not just be for the benefit of older people. They will also find use in children and younger adults since the use of chemicals and radiation for cancer therapy artificially accelerates the ageing process. Furthermore, it is known that some infections, such as HIV, also accelerate the ageing process.
Cancer support
CCT also provides special ‘Youth2Go’ Healing Holidays of creative adventure for children recovering from cancer, enabling them to regain their self-confidence and re-ignite their passion for life after the trauma of their illness and lengthy treatment. In addition, they provide financial support for adult cancer sufferers to ameliorate their sickness, improve their quality of life, limit their stress and, where possible, help their recovery.
A cancer-free future
CCT-funded research aims to increase understanding of how silent infections, lifestyle, diet, genetic predisposition and environmental pollution lead to different types of cancer in children and adults. Indeed they have identified simple changes in lifestyle and diet which, combined with avoidance of exposure to environmental contaminants, will reduce the incidence of cancer in all age groups.
The CCT aims to identify and understand hitherto-unknown cause-and-effect relationships to either limit exposure to such carcinogenic factors or devise therapies which suppress their effects before a cancer has developed.
Prevention now saves treatment later
The CCT research mission for cancer prevention involves:
• New lifesaving cancer prevention medicines
Funding
Caring Cancer Trust’s Stopcancer programme is entirely managed and run by unpaid volunteers and financed by legacies and donations. A gift to them funds animal-free research into cancer treatment and prevention as well as Youth2Go creative adventure holidays for children recovering from cancer.
In short, they aim to create a cancer-free tomorrow for the children of today. q
For the last 12 months, the CCT has been funding the University of Manchester spinout company Ravan Bio Ltd to develop a novel antiaging treatment to prevent cancer and the other age-related diseases. Ravan’s new therapy is taken orally, has no side effects and is very safe. Furthermore, indications are it is extremely successful resulting in a >80% reduction in the biological age of test subjects and it is anticipated this work has great potential for the prevention of cancer and other age-related ailments.
• New therapies for cancers in their early
• stages
• Analysis of the role of microbes in causing
• cancer
• New therapies for later-life cancers
• Heightened cancer awareness by GPs and
• public
• Lifestyle, diet and environmental changes for
• cancer avoidance
• Dissemination of trial results relating to
• cancer treatment and prevention
